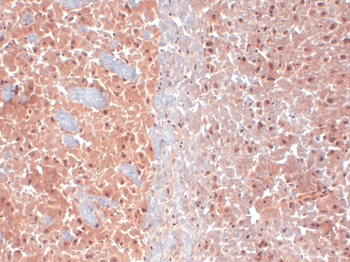
产品细节图片2

产品描述:Mouse monoclonal to KCNQ4 (HRP). Ion channels are integral membrane proteins that help establish and control the small voltage gradient across the plasma membrane of living cells by allowing the flow of ions down their electrochemical gradient. They are present in the membranes that surround all biological cells because their main function is to regulate the flow of ions across this membrane. Whereas some ion channels permit the passage of ions based on charge, others conduct based on a ionic species, such as sodium or potassium. Furthermore, in some ion channels, the passage is governed by a gate which is controlled by chemical or electrical signals, temperature, or mechanical forces. There are a few main classifications of gated ion channels. There are voltage- gated ion channels, ligand- gated, other gating systems and finally those that are classified differently, having more exotic characteristics. The first are voltage- gated ion channels which open and close in response to membrane potential. These are then separated into sodium, calcium, potassium, proton, transient receptor, and cyclic nucleotide-gated channels; each of which is responsible for a unique role. Ligand-gated ion channels are also known as ionotropic receptors, and they open in response to specific ligand molecules binding to the extracellular domain of the receptor protein. The other gated classifications include activation and inactivation by second messengers, inward-rectifier potassium channels, calcium-activated potassium channels, two-pore-domain potassium channels, light-gated channels, mechano-sensitive ion channels and cyclic nucleotide-gated channels. Finally, the other classifications are based on less normal characteristics such as two-pore channels, and transient receptor potential channels. Specifically, the protein encoded by this gene forms a potassium channel that is thought to play a critical role in the regulation of neuronal excitability, particularly in sensory cells of the cochlea. The current generated by this channel is inhibited by M1 muscarinic acetylcholine receptors and activated by retigabine, a novel anti-convulsant drug.
别名:KCNQ4, Kv7.4, KVLQT4, Potassium voltage-gated channel subfamily KQT member 4, Voltage-gated potassium channel subunit Kv7.4, KQT-like 4, Potassium channel subunit alpha KvLQT4, Potassium voltage-gated channel KQT-like subfamily member 4, DFNA2, KCNQ4_HUMAN, Kcnq4, KCNQ 4, Potassium channel KQT like 4, Potassium voltage gated channel KQT like protein 4, Voltage gated potassium channel subunit Kv7.4
免疫原:Fusion protein amino acids 2-77 of human KCNQ4
克隆性:N43/6 (Formerly sold as S43-6)
分子量:77kDa
应用稀释比例:WB (1:1000), IHC (1:1000), ICC/IF (1:100)
应用注释:1 µg/ml of SMC-309 was sufficient for detection of KCNQ4 in 10 µg of COS-1 cell lysate transiently expressing KCNQ4 by colorimetric immunoblot analysis using Goat anti-mouse IgG:HRP as the secondary antibody.
防腐剂:73.64mM Carbonate, 54.55mM Ethanolamine, 45.45mM Cyanoborohydride, 18.18mM Sodium Hydroxide 0.23mM Citrate
纯化:Protein G Purified
保存说明:Conjugated antibodies should be stored according to the product label
NCBI:NP_004691.2
Entrez:9132
UniProt ID:P56696
Note:For research use only.
Immunocytochemistry/Immunofluorescence analysis using Mouse Anti-KCNQ4 Monoclonal Antibody, Clone N43/6. Tissue: Neuroblastoma cells (SH-SY5Y). Species: Human. Fixation: 4% PFA for 15 min. Primary Antibody: Mouse Anti-KCNQ4 Monoclonal Antibody at 1:100 for overnight at 4°C with slow rocking. Secondary Antibody: AlexaFluor 488 at 1:1000 for 1 hour at RT. Counterstain: Phalloidin-iFluor 647 (red) F-Actin stain; Hoechst (blue) nuclear stain at 1:800, 1.6mM for 20 min at RT. (A) Hoechst (blue) nuclear stain. (B) Phalloidin-iFluor 647 (red) F-Actin stain. (C) KCNQ4 Antibody (D) Composite.
Immunohistochemistry analysis using Mouse Anti-KCNQ4 Monoclonal Antibody, Clone N43/6. Tissue: frozen brain section. Species: Mouse. Fixation: 10% Formalin Solution for 12-24 hours at RT. Primary Antibody: Mouse Anti-KCNQ4 Monoclonal Antibody at 1:1000 for 1 hour at RT. Secondary Antibody: HRP/DAB Detection System: Biotinylated Goat Anti-Mouse, Streptavidin Peroxidase, DAB Chromogen (brown) for 30 minutes at RT. Counterstain: Mayer Hematoxylin (purple/blue) nuclear stain at 250-500 μl for 5 minutes at RT.
Western Blot analysis of Rat tissue lysate showing detection of KCNQ4 protein using Mouse Anti-KCNQ4 Monoclonal Antibody, Clone N43/6. Load: 15 μg. Block: 1.5% BSA for 30 minutes at RT. Primary Antibody: Mouse Anti-KCNQ4 Monoclonal Antibody at 1:1000 for 2 hours at RT. Secondary Antibody: Sheep Anti-Mouse IgG: HRP for 1 hour at RT.
Immunohistochemistry analysis using Mouse Anti-KCNQ4 Monoclonal Antibody, Clone N43/6. Tissue: hippocampus. Species: Human. Fixation: Bouin's Fixative and paraffin-embedded. Primary Antibody: Mouse Anti-KCNQ4 Monoclonal Antibody at 1:1000 for 1 hour at RT. Secondary Antibody: FITC Goat Anti-Mouse (green) at 1:50 for 1 hour at RT.